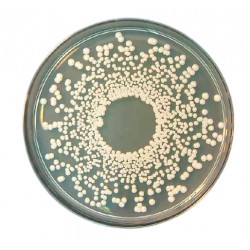
Potato Dextrose Agar, 500GM

Culture media are used for quality control tests of nonsterile raw materials and finished products as well as for microbial contamination (sterility) tests in applications such as hygiene monitoring, sterilization process validation, and determination of the effectiveness of preservatives and antimicrobial agents.
Principle: In preparing a culture medium for any microorganism, the primary goal is to provide a balanced mixture of the required nutrients, at concentrations that will permit good growth. No ingredient should be given in excess because many nutrients become growth inhibitory or toxic as the concentration is raised.
Two compositions of culture
As this definition suggests, there are two basic components of culture: ideas and symbols on the one hand and artifacts (material objects) on the other. The first type, called nonmaterial culture also known as symbolic culture, includes the values, beliefs, symbols, and language that define a society.
Preparation of microbiological media
Stir and boil the agar medium to get the agar powder dissolved (if making an agar medium rather than a broth medium) distribute the medium into tubes. autoclave to sterilize the tube media. autoclave the agar medium for plate production and then pour into sterile Petri dishes.

Leave a Comment